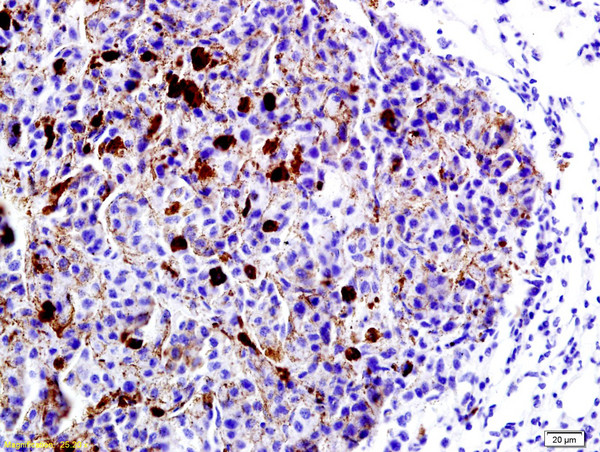
LRP1/CD91 Antibody in Immunohistochemistry (Paraffin) (IHC (P))

Search
Bioss
LRP1/CD91 Polyclonal Antibody
{{$productOrderCtrl.translations['antibody.pdp.commerceCard.promotion.promotions']}}
{{$productOrderCtrl.translations['antibody.pdp.commerceCard.promotion.viewpromo']}}
{{$productOrderCtrl.translations['antibody.pdp.commerceCard.promotion.promocode']}}: {{promo.promoCode}} {{promo.promoTitle}} {{promo.promoDescription}}. {{$productOrderCtrl.translations['antibody.pdp.commerceCard.promotion.learnmore']}}
产品信息
BS-2677R
种属反应
宿主/亚型
分类
类型
抗原
偶联物
形式
浓度
规格
纯化类型
保存液
内含物
保存条件
运输条件
靶标信息
CD91 is a 600 kDa type I transmembrane protein composed of an alpha and beta chain. The alpha chain interacts with a variety of structurally and functionally diverse ligands, while the beta chain contains two tyrosine phosphorylation motifs that interact with adaptor and signaling proteins. This receptor is expressed by cells in the monocytic lineage, dendritic cells, hepatocytes, fibroblasts, adipocytes, neurons, and syncytiotrophoblasts. CD91 plays a crucial role in several cellular processes, including ligand endocytosis and trafficking to lysosomes, intracellular signaling, lipid homeostasis, and clearance of apoptotic cells. It is involved in cross-presenting antigens via MHC class I molecules on antigen-presenting cells after endocytosis of heat shock protein-peptide complexes. Additionally, CD91 is essential for the A2M-mediated clearance of secreted amyloid precursor protein and beta-amyloid, the main component of amyloid plaques found in Alzheimer patients. Expression of CD91 decreases with age and is found to be lower in brain tissue from Alzheimer patients compared to controls. The receptor also plays a role in cell migration and activating signaling cascades, highlighting its importance in both immune function and disease processes.
仅用于科研。不用于诊断过程。未经明确授权不得转售。
篇参考文献 (0)
生物信息学
蛋白别名: A2MR; alpha 2-macroglobulin receptor; Alpha-2-macroglobulin receptor; APOER; Apolipoprotein E receptor; CD91; FLJ16451; lipoprotein receptor-related protein; low density lipoprotein receptor-related protein 1; low density lipoprotein-related protein 1 (alpha-2-macroglobulin receptor); LRP-1; lrp1; MGC88725; Prolow-density lipoprotein receptor-related protein 1; TbetaR-V/LRP-1/IGFBP-3 receptor; type V tgf-beta receptor
基因别名: A2MR; AI316852; APOER; APR; b2b1554Clo; CD91; DDH3; IGFBP-3R; IGFBP3R; IGFBP3R1; KPA; LRP; LRP1; LRP1A; TGFBR5
UniProt ID: (Human) Q07954, (Mouse) Q91ZX7, (Rat) G3V928
Entrez Gene ID: (Human) 4035, (Mouse) 16971, (Rat) 299858